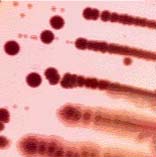
（圖）耶爾森氏菌病

耶爾森氏菌
耶爾森氏菌耶爾森氏菌病是由小腸結腸炎耶爾森菌引起的一種人畜共患感染病。臨床表現以急性胃腸炎小腸結腸炎和敗血症等類型為主亦有急性闌尾炎、腦膜炎、多發性關節炎、猩紅熱型、黃疸型和淋巴細胞白血病等多種臨床類型,部分病例有慢性傾向。病人、健康帶菌者以及患病和帶菌的家畜攜帶的病原體,主要是通過污染的飲水和食品經消化道傳播。人群普遍易感,15歲以下兒童多發。多為散發,冬春發病較多見由於耶爾森氏菌在低溫中能生長,所以保存在4℃冰櫃中的食品更具傳染性。
分類
耶爾森氏菌為動物腸道寄生菌,廣泛存在於動物體內。本菌在外界環境(河水、井水、蒸餾水)中不僅可長期生存,而且可以繁殖。該菌有嗜冷性,食品一旦被污染,在冷藏中仍能繼續繁殖,故該病冬季多發。現代文明的“電冰櫃腸炎”致病菌,就是人獸共同的耶爾森氏菌。
耶爾森氏菌屬包括11個種,其中對人有致病性的有三種:小腸結腸炎耶爾森氏菌、假結核菌和鼠疫菌。只有小腸結腸炎耶爾森氏菌和假結核菌已確定是食源性病原體。鼠疫耶爾森氏菌引起黑疽病,不通過食品傳染。1981年根據DNA以及生化和形態特徵的相關資料,與小腸結腸炎耶爾森氏菌極為密切3個同源群被作為耶爾森氏菌的新種命名,它們是弗氏耶爾森氏菌(Y·frederiksenii)、中間型耶爾森氏菌(Y·intermedia)和克氏耶爾森氏菌。
臨床表現
 耶爾森氏菌
耶爾森氏菌小腸結腸炎耶爾森氏菌是20世紀30年代引起注意的急性胃腸炎型食物中毒的病原菌,為人畜共患病。潛伏期約攝食後3-7天,也有報導11天才發病。病程一般為1-3天,但有些病例持續5-14天或更長。主要症狀表現為發熱、腹痛、腹瀉、嘔吐、關節炎、敗血症等。耶爾森氏菌病典型症狀常為胃腸炎症狀、發熱、亦可引起闌尾炎。有的引起反應性關節炎,另一個併發症是敗血症,即血液系統感染,儘管較少見,但死亡率較高。本菌對易染人群為嬰幼兒,常引起發熱、腹痛和帶血的腹瀉。
偽結核耶爾森氏菌可引起斷奶豬與生長豬發病,表現為輕度發熱,眼瞼、面部及腹部腫脹,腹瀉,糞便中帶有黏液和血液。小腸結腸耶爾森氏菌可導致斷奶豬腸道臌脹、腹瀉,間歇性排出糊狀稀糞,糞便中混有黏液和腸黏膜脫落物,糞便表面常有紅色或暗褐色血液,有時在較成形的糞便表面附著一層灰白色、油光發亮的薄膜。豬體溫一般正常,少數升高到40℃以上。病程長的病豬,食慾差,消瘦,被毛粗糙,步態不穩。死亡率不高,但生長發育受阻。仔豬可因脫水休剋死亡。成年豬常可耐過。
流行病學
 耶爾森氏菌
耶爾森氏菌細菌分布
小腸結腸炎耶爾森氏菌分布很廣,可存在於生的蔬菜、乳和乳製品、肉類、豆製品、沙拉、牡蠣、哈和蝦。也存在於環境中,如湖泊、河流、土壤和植被。已從家畜、狗、貓、山羊、灰鼠、水貂和靈長類動物的糞便中分離出該菌。在港灣周圍,許多鳥類包括水禽和海鷗可能是帶菌者。豬的帶菌率較高,日本報告檢出率為4%,加拿大為3.6%,丹麥為10-17%。在豬中,該菌最易在扁桃腺中發現。
中國情況
中國已從人和豬牛禽等動物體中分離出10餘個血清型。湖北省1985-1986年,對雞鴨牛豬4種禽畜,總計4218份糞便樣品進行了檢查,共檢出耶爾森氏菌131株。平均陽性率3.1%。其中雞1130隻,檢出17株。牛1127頭,檢出30株。豬1120頭,檢出70株。鴨847隻,檢出24株。耶爾森氏菌儲存宿主以豬為最高,牛次之。豬是傳播該病的重要宿主。福建某豬場對仔豬進行細菌分離,陽性率為30%,血清陽性率高達70%。南京市檢查健康人的糞便28份,帶菌率為0.7%;豬234份,帶菌率為72.6%;犬37份,帶菌率為16.4%;鼠101份,帶菌率為8.81%。山東濰坊市檢查牛奶74份,陽性2份,羊奶152份,陽性5份。
人畜感染特點
仔豬患病,每天腹瀉10一15次,呈灰白色或灰綠色糊狀稀便,常混有粘液,紅色或暗紅色血液和腸黏膜脫落物。糞便外表常包裹著一層灰白色發亮的薄膜,一般體溫不高。貓患病主要表現厭食,嘔吐,腹瀉,消瘦,黃疽,痙攣等症狀。兔發病表現嚴重腹瀉,呼吸困難,運動失調。牛羊多表現腹瀉、流產。人飲用或食用了被污染的水和食物,經消化道感染,主要表現發熱、噁心、嘔吐、腹痛、腹瀉、頸部淋巴結腫大。常伴有膿腫和膿血症。
檢查
耶爾森菌
耶爾森菌實驗室檢查:
1、末梢血白細胞計數及中性粒細胞可增多,血沉常加快,大便鏡檢可見白細胞和紅細胞。
2、從病變部位留取標本如大便、血、尿、痰、腦脊液、腸系膜淋巴結等均可分離出耶爾森菌。
3、血清學檢查
①恢復期血清凝集試驗較急性期效價呈4倍以上增長或滴度1∶160以上有診斷意義。
②血清抗耶爾森菌外膜蛋白IgA,IgG檢測較凝集試驗特異性更強。
4、其他可用免疫螢光法檢測活檢標本中的耶爾森菌抗原以常規PCR方法檢測臨床及食物標本中小腸結腸炎耶爾森菌和假結核耶爾森菌以及PCR-探針相結合方法、Nested-PCR方法檢測小腸結腸炎耶爾森菌。
相關檢查:
> 免疫球蛋白A
> 免疫球蛋白G
> 白細胞計數
> 腦脊液
> 血小板
> 血沉
治療
腸道感染一般為自限性,僅需對症處理,可不用抗菌藥物治療。病情嚴重,特別是有腸道外感染者應予以抗菌藥物治療首選氟喹諾酮類藥物,氧氟沙星每天600mg,分2~3次口服,3~5天為一療程。敗血症者可靜脈給藥可用氧氟沙星或呋布西林、美洛西林、頭孢噻肟和拉氧頭孢等耐β-內醯胺酶抗生素。有膿腫者應切開引流。
病原研究
 耶爾森氏菌病發病載體
耶爾森氏菌病發病載體生物型
共有5型,1型和5型多為非致病株,2、3、4型為致病株。中國分離到O∶3和O∶9血清型菌株均為生物3型,而國外分別為生物4型和2型,構成國內外致病性的差異。
噬菌體
中國1981年分離出第一株耶氏菌噬菌體,1983年又分離出42株噬菌體,這些噬菌體是以O∶3型耶氏菌為指示菌分離的,裂解範圍很狹窄,在15℃只裂解O∶3型耶氏菌,其他47個血清型均不裂解,對鼠疫耶氏菌、假結核耶氏菌、大腸菌、志賀氏菌、沙門氏菌也不裂解。以後以48型耶氏菌為指示菌,從231份豬便,分離出110株噬菌體,這些噬菌體裂解範圍各不相同,其中兩株噬菌體(JA和HB)裂解範圍廣,兩者混合後,可裂解各型耶氏菌的97%,而對580株其他腸道菌的裂解率不到1%,故可作為耶氏菌的初步診斷和鑑定用。噬菌體對增菌培養的影響。耶氏菌分離常用增菌培養法,以提高檢出率。如被檢標本中有噬菌體存在,則會降低檢菌率,反而不如直接平板培養法高。噬菌體作用下典型耶氏菌向非典型耶氏菌轉變。據報導,32株O∶3型耶氏菌經本型菌噬菌體作用後,有3株再生菌生化反應發生變化,能分解鼠李糖、蔗糖,不分解蜜二糖。根據Brenner等(1980年)分類法,這3株轉變為弗氏耶氏菌(Yersinia frederiksenii),這種情況在自然界和體內都可能存在。
耶氏菌毒力研究
耶氏菌血清型很多,根據其毒力,可分為兩大類:一類對人有致病力;另一類對人類無致病力,大部分血清型屬於後者。但研究證明,屬於致病性血清型的菌株中,也有喪失致病力的。國外測毒方法有Vw抗原、自凝性、質粒、剛果紅、腸毒素、Sereny試驗、小鼠眼球後測毒等法。這些方法在中國都有試用過,獲得的結果表明這些方法都是比較敏感和特異的,但常見不一致的情況。Vw抗原與自凝因子,是國內外鑑別耶氏菌毒力株與無毒株常用的方法,兩法都很敏感和特異,符合率也很高,可作為測毒方法之一,但比較麻煩費時。Vi抗原:為中國首次報導,與菌株毒力密切相關,與Vw抗原和自凝因子符合率很高,屬於種特異性,各種血清型是共同的,即用一種血清型的Vi抗血清,可把各型菌株的毒力株都查出來,1min內即可得結果,重複性強,是一種最簡便快速的優秀測毒方法,可以代替Vw抗原和自凝因子測毒法。毒力質粒:耶氏菌含有大小不同的質粒,其中(40~50)×106質粒,與菌株毒力有關。國外文獻稱其為毒力質粒。中國研究證明攜帶(40~50)×106質粒的菌株,並非都是毒力株,要視菌株是否含有分子量為200×103溫度依賴的外膜蛋白而定。即含有200×103左右的外膜蛋白者為毒力株,測不出200×103外膜蛋白者為無毒株。由此可見,一個菌株檢測出(40~50)×106質粒,就認為是毒力株是不全面的。
鑑別
 耶爾森氏菌
耶爾森氏菌耶氏森氏菌與布魯氏菌抗體的血清學交叉反應,國內外曾試圖採用各種方法加以鑑別,直到現在均未獲滿意結果。嚴延生等(1988年)以O:9型耶氏菌外膜蛋白為抗原的免疫印跡法,可明顯地鑑別O∶9型耶氏菌和布魯氏菌兩種抗體。於恩庶等(1991年)進一步以O:3型耶氏菌質粒編碼的電泳性和免疫原性與0∶9型耶氏菌相同,故改用O∶3型代替O∶9型耶氏菌外膜蛋白為抗原的免疫斑點試驗或免疫印跡試驗鑑別O∶9型耶氏菌和布魯氏菌兩類抗體更為明確。採用這種方法糾正了用布病常規血清學方法錯判的布病患者和布病疫源地。魯齊發等(1993年)也證明採用SAT、ELISA及DIBA分別對6種布魯氏菌及耶氏菌O:9型感染兔血清抗體,無論用布魯氏菌104 m、耶氏菌O∶9型凝集抗原做SAT檢查,或用布魯氏菌16 M超音波破碎抗原做ELISA檢查,均無鑑別意義;而用16 m可溶性蛋白抗原、外膜蛋白抗原以及用耶氏菌O∶3型可溶性蛋白抗原、外膜蛋白抗原做ELISA或DIBA均能鑑別布魯氏菌與耶氏菌O∶9型兩種抗體,在實際檢測時,以同時用10 m及O∶3型外膜蛋白做ELISA檢查為宜。
防制措施
1、嚴格控制傳染源,隔離可疑病人或病人,嚴格執行檢疫制度;
2、切斷傳播途徑,滅鼠、滅蚤;
3、提高人群免疫力(預防接種鼠疫無毒活疫苗)和個人防護。
預後:
一般預後較好,有嚴重基礎疾病合併敗血症者病死率可達50%~75%。
研究進展
 鼠疫
鼠疫1、鼠疫耶爾森氏菌16S-23SrRNA基因間區分析展種快速準確的鑑定鼠疫菌的方法。方法 PCR反應加限制性內切酶消化的方法。結果對來自不同疫源地的103株鼠疫菌16S-23S rRNA基因間區進行擴增,均可擴出兩條長為1 146bp及1090bp的片段,擴增產物用限制性內切酶Taq I,Msp I消化後的酶切圖譜相同。而對照菌株小腸結腸炎耶爾森氏菌,鼠傷寒沙門氏菌,大腸桿菌,痢疾桿菌,霍亂弧菌的擴增產物及酶切圖譜與鼠疫菌均不相同。結論是鼠疫菌16S-23S rRNA基因間區高度同源,基本為兩種類型,長度分別為1 146bp及1 090bp,其他菌株與其明顯不同;該方法將有助於快速準確的鑑定鼠疫菌。
2、中國耶氏菌病最主要的病原菌是O∶3 和O∶9 血清型,這與歐洲和日本等國家是相同的,但其生物型則完全不同,即中國O∶3 和O∶9 兩種血清型,均以生物3 型為主,而國外前者以生物4 型為主,後者以生物2 型為主。致病力也有差異,中國O∶3 型菌株致病力強,國外報告的菌株弱。
3、中國O∶3 型耶氏菌能引起豬腹瀉,已發現兩次豬耶氏菌腹瀉的暴發流行,而國外認為豬系正常帶菌,不致病。
4、昆蟲的傳播作用:在國外被忽視,缺乏這方面的資料。中國的調查研究證實,蒼蠅和蟑螂體內帶菌時間相當長,並能通過糞便向外排出,污染外部環境和食品,起到了傳播作用.
5、研究出一種新的免疫學方法———酶免疫斑點試驗:能把耶氏菌屬的3個致病菌(鼠疫、假結核和小腸結腸炎耶爾森氏菌)的毒力株都能測出來,此乃耶氏菌屬的一種簡便、快速、共同的測毒方法。
